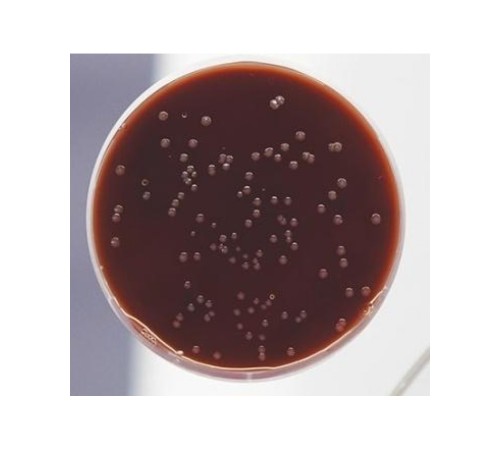
Питательная среда для выделения и культивирования кампилобактерий сухая (Кампилобакагар)

Не является лекарственным (фармацевтическим) препаратом. Не является БАД.
Не предназначен для проведения любых медицинских исследований или процедур.
Продажу химических реактивов осуществляем только юридическим лицам.
Приготовление: Препарат в количестве, указанном на этикетке для приготовления конкретной серии питательной среды, размешивают в 1 л дистиллированной воды и стерилизуют автоклавированием при температуре 121°С в течение 15 мин.В охлажденную после стерилизации до температуры 45-50 °С среду стерильно добавляют 70 мл лошадиной дефибринированной крови, или цельной бараньей, или лизиро-ванной человеческой донорской крови и разливают в стерильные чашки Петри.
Готовая среда должна быть красного цвета.
Посев и учет результатов бактериологического исследования проводят в соответствии с “Инструкцией по клинической и лабораторной диагностике кампилобактериоза” МЗ СССР 1989г.
При использовании среды для выделения кампилобактерий необходимо добавить раствор смеси антибиотиков следующего состава: полимиксин В - 2 мг/л; рифампицин - 10 мг/л; амфотерицин В - 3 мг/л (из расчета содержимое одного флакона на 1 л среды). Для этого в пенициллиновый флакон с антибиотиками добавляют асептически 4 мл сте-рильной дистиллированной воды и 0,05 мл диметилсульфоксида (или 5-7 капель этилового спирта). Смесь растворяется при тщательном перемешивании.
Питательная среда должна обеспечивать рост тест-штамма Campylobacter jejuni 11168 из разведения 10-7 взвеси в виде единичных, светло-серых, слизистых колоний в S-форме диаметром 1,0-1,5 мм при посеве 0,1 мл взвеси на всех засеянных чашках. Сопут-ствующая микрофлора на кампилобакагаре не растет, за исключением протеев.
Хранить в герметически закрытой упаковке в темном месте в помещении с относительной влажностью воздуха не более 60 % и температурой от 2 до 30°С.
Цена дана с учетом НДС 20% за 1 банку 250 г.
Нет отзывов об этом товаре.
Нет вопросов об этом товаре.
Доставка заказов осуществляется в любые регионы Российской Федерации и страны СНГ.
Цены на нашем сайте указаны с учетом НДС (20% либо 10%).
Оплата заказов производится только в безналичной форме на расчетный счет в рублях Российской Федерации на основании выставленного Счета.
Для бюджетных организаций и государственных структур предусмотрены особые условия оплаты.
Постоянным клиентам предоставляются скидки и индивидуальный порядок расчетов.
Внимание! В связи с нестабильным курсом валют и изменением цен у производителей, просим окончательную стоимость продукции уточнять у наших менеджеров.
Варианты доставки:
Самовывоз со склада в городе Клин
Адрес выдачи: Московская область, г. Клин, ул. Захватаева, д. 4, офис 101
Контактный телефон: +7 (977) 407-05-96
Доставка по Клину и Клинскому району – бесплатно
Доставка по Москве – 1 500 рублей
Доставка любыми транспортными компаниями, службами экспресс-доставки. Стоимость рассчитывается индивидуально для каждого заказа в соответствии с установленными тарифами транспортной компании. Все грузы застрахованы.
Компания "КомплектСнаб является официальным поставщиком от производителя ФБУН ГНЦ ПМБ Оболенск. Вы всегда можете получить бесплатную консультацию по продукции, получить КП и задать вопросы по подбору аналогов продукции.








